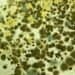
DIY Mold Testing Kits: The Truth about Their Value and Effectiveness

Indoor air quality (IAQ) is a crucial aspect of our daily lives that can have a significant impact on our health. With people spending more time indoors than ever before, it’s essential to understand the fundamentals of IAQ and its role in immune system health. Poor IAQ can lead to a range of health problems, from allergies and asthma to more severe respiratory issues.

The components of indoor air, such as pollutants, allergens, and other harmful substances, can have a significant impact on our immune system’s ability to function correctly. This is especially true for vulnerable populations, such as children, the elderly, and those with pre-existing health conditions. Understanding the link between IAQ and immune response is essential for maintaining a healthy home or workplace.
Key Takeaways
- Indoor air quality is a critical aspect of our daily lives that can impact our health.
- Poor IAQ can lead to a range of health problems, especially for vulnerable populations.
- Understanding the link between IAQ and immune response is essential for maintaining a healthy home or workplace.
Fundamentals of Indoor Air Quality

Indoor air quality (IAQ) refers to the quality of air within and around buildings and structures. It is important to maintain good IAQ as it can have a significant impact on the health and well-being of occupants. Poor IAQ can cause a range of health problems such as headaches, fatigue, respiratory problems, and allergies.
The quality of indoor air is affected by a variety of factors such as temperature, humidity, ventilation, and the presence of pollutants. Pollutants can come from both indoor and outdoor sources such as cleaning products, tobacco smoke, mold, and outdoor air pollution. It is important to identify and eliminate sources of pollutants to maintain good IAQ.
One way to improve IAQ is to ensure proper ventilation. Ventilation helps to remove pollutants from indoor air and bring in fresh outdoor air. This can be achieved through natural ventilation such as opening windows or through mechanical ventilation systems such as fans and air conditioning units.
Another way to improve IAQ is to use air purifiers. Air purifiers can help to remove pollutants such as dust, pollen, and mold spores from indoor air. It is important to choose an air purifier that is appropriate for the size of the room and the type of pollutants present.
In summary, maintaining good IAQ is important for the health and well-being of occupants. Proper ventilation and the use of air purifiers can help to improve IAQ by removing pollutants from indoor air.
Components of Indoor Air and Their Impact on Health

Particulate Matter and Allergens
Particulate matter (PM) and allergens are tiny particles that can be found in indoor air. PM can come from sources such as tobacco smoke, cooking, and outdoor pollution, while allergens can come from sources such as pets, dust mites, and mold. These particles can irritate the respiratory system and worsen symptoms for individuals with allergies or asthma. It is important to regularly clean and vacuum indoor spaces to reduce the presence of these particles.
Volatile Organic Compounds (VOCs)
Volatile organic compounds (VOCs) are chemicals that can be found in indoor air from sources such as cleaning products, paint, and furniture. These chemicals can have negative effects on respiratory health and can cause symptoms such as headaches, dizziness, and irritation of the eyes, nose, and throat. Choosing low-VOC products and ensuring proper ventilation can help reduce exposure to these chemicals.
Carbon Dioxide Levels
Carbon dioxide (CO2) is a gas that can accumulate in indoor spaces from sources such as human breath and combustion appliances. High levels of CO2 can cause symptoms such as headaches, dizziness, and fatigue. Proper ventilation and monitoring of CO2 levels can help ensure healthy indoor air quality.
Humidity and Mold Growth
Humidity levels that are too high can promote the growth of mold, which can worsen respiratory symptoms and cause allergic reactions. It is important to maintain proper humidity levels and promptly address any mold growth in indoor spaces. Using dehumidifiers and ensuring proper ventilation can help prevent mold growth.
Immune System Basics
The immune system is the body’s defense mechanism against harmful pathogens such as bacteria, viruses, and fungi. It is a complex network of cells, tissues, and organs that work together to protect the body from infection and disease.
Innate Immunity
The innate immune system is the body’s first line of defense against pathogens. It includes physical barriers such as the skin and mucous membranes, as well as various cells and proteins that can quickly recognize and respond to foreign invaders.
One of the key cells involved in innate immunity is the macrophage, which can engulf and destroy pathogens. Other cells, such as natural killer cells and dendritic cells, can also help to recognize and eliminate foreign invaders.
Adaptive Immunity
The adaptive immune system is a more specialized defense mechanism that can provide long-term protection against specific pathogens. It involves the production of antibodies, which can recognize and neutralize specific antigens on the surface of pathogens.
Adaptive immunity is mediated by specialized cells called lymphocytes, which can recognize and respond to specific antigens. There are two types of lymphocytes: B cells, which produce antibodies, and T cells, which can directly attack infected cells.
Overall, the immune system is a complex and sophisticated network of cells and organs that work together to protect the body from infection and disease. By understanding the basics of innate and adaptive immunity, we can better appreciate the importance of maintaining good indoor air quality to support a healthy immune system.
Link Between Indoor Air Quality and Immune Response
Indoor air quality is an important factor that can influence the immune system’s response to various pathogens. Exposure to air pollutants can lead to respiratory infections, which can weaken the immune system and make it more susceptible to other diseases. Chronic exposure to indoor air pollutants can also modulate the immune system, leading to an increased risk of autoimmune disorders.
Air Pollutants and Respiratory Infections
Indoor air pollutants such as particulate matter, volatile organic compounds (VOCs), and nitrogen dioxide (NO2) can cause respiratory infections. These pollutants can irritate the respiratory tract and cause inflammation, making it easier for pathogens to infect the body. Exposure to these pollutants can also weaken the immune system, making it harder for the body to fight off infections.
Chronic Exposure and Immune System Modulation
Chronic exposure to indoor air pollutants can lead to immune system modulation, which can increase the risk of autoimmune disorders. This is because chronic exposure to pollutants can cause the immune system to become overactive, leading to an increased risk of inflammation and tissue damage. Over time, this can lead to the development of autoimmune disorders such as rheumatoid arthritis, lupus, and multiple sclerosis.
In conclusion, indoor air quality plays an important role in immune system health. Exposure to air pollutants can weaken the immune system and make it more susceptible to respiratory infections. Chronic exposure to pollutants can also modulate the immune system, leading to an increased risk of autoimmune disorders. It is important to take steps to improve indoor air quality to protect the immune system and promote overall health.
Assessing Indoor Air Quality

Indoor air quality (IAQ) can have a significant impact on human health, particularly the immune system. Therefore, it is essential to assess the indoor air quality regularly to ensure a healthy living environment.
Monitoring Devices and Techniques
There are several monitoring devices and techniques available to assess indoor air quality. Some of the commonly used devices include:
- Air Quality Meters: These devices measure the concentration of pollutants in the air, such as carbon dioxide, carbon monoxide, and volatile organic compounds (VOCs).
- Particle Counters: These devices measure the number and size of particles in the air, including dust, pollen, and mold spores.
- Thermal Hygrometers: These devices measure temperature and humidity levels in the air.
In addition to these devices, there are also several techniques used to assess indoor air quality, such as:
- Visual Inspection: A visual inspection can identify visible signs of mold, moisture, and other contaminants.
- Air Sampling: Air sampling involves collecting air samples and analyzing them in a laboratory to identify the presence of pollutants, such as bacteria, viruses, and allergens.
- Building Diagnostics: Building diagnostics involve evaluating the building’s HVAC system, ventilation, and other factors that can affect indoor air quality.
Interpreting IAQ Data
Once the indoor air quality has been assessed, the data must be interpreted to determine if any corrective actions are necessary. The interpretation of IAQ data requires an understanding of the acceptable levels of pollutants and other contaminants in the air.
The acceptable levels of pollutants and contaminants vary depending on the type of pollutant and the level of exposure. For instance, the acceptable level of carbon dioxide in the air is 400-1000 parts per million (ppm), while the acceptable level of mold spores is less than 500 colony-forming units per cubic meter (CFU/m³).
In conclusion, assessing indoor air quality is essential for maintaining a healthy living environment. By using monitoring devices and techniques and interpreting IAQ data, homeowners and building managers can identify and address any potential health hazards.
Improving Indoor Air Quality for Immune Health
Indoor air quality plays a critical role in maintaining a healthy immune system. Poor indoor air quality can lead to various respiratory and immune system problems, including allergies, asthma, and other respiratory infections. Fortunately, there are several ways to improve indoor air quality and promote a healthy immune system.
Ventilation and Air Purification
Proper ventilation is essential for maintaining good indoor air quality. It helps to remove pollutants and toxins from the air and improves air circulation. It is recommended to open windows and doors regularly to let fresh air in and allow stagnant air to escape. In addition to natural ventilation, air purifiers can also be used to remove pollutants and allergens from the air. High-efficiency particulate air (HEPA) filters are particularly effective in removing airborne particles, including viruses and bacteria.
Natural and Mechanical Filtration Systems
Natural filtration systems, such as plants, can help to remove pollutants from the air. Plants absorb carbon dioxide and release oxygen, which improves air quality. Some plants, such as spider plants and peace lilies, are particularly effective at removing pollutants like formaldehyde and benzene from the air. Mechanical filtration systems, such as air filters and air cleaners, can also help to remove pollutants and allergens from the air.
Regulating Humidity and Temperature
Maintaining proper humidity and temperature levels is essential for good indoor air quality. High humidity levels can promote the growth of mold and bacteria, while low humidity levels can lead to dry skin and respiratory problems. It is recommended to keep humidity levels between 30% and 50%. Temperature can also affect indoor air quality. High temperatures can increase the concentration of pollutants and allergens in the air, while low temperatures can promote the growth of mold and bacteria. It is recommended to keep indoor temperatures between 68°F and 72°F.
By implementing these measures, individuals can significantly improve indoor air quality and promote a healthy immune system.
Best Practices for Maintaining Healthy Indoor Air
Routine Maintenance and Cleaning
Regular maintenance and cleaning of HVAC systems, air filters, and air ducts is essential for maintaining healthy indoor air quality. Dirty air filters can cause a buildup of dust, pollen, and other allergens, which can exacerbate respiratory issues and weaken the immune system. It is recommended to change air filters every three months, or more frequently if necessary.
Additionally, regular cleaning of surfaces, carpets, and upholstery can help reduce the amount of dust and allergens in the air. Using a vacuum cleaner with a HEPA filter can be particularly effective in removing small particles from the air.
Building Design and Material Choices
Building design and material choices can also have a significant impact on indoor air quality. Choosing low-emitting materials, such as paints, adhesives, and carpets, can help reduce the amount of harmful chemicals released into the air. Proper ventilation and natural lighting can also help improve air quality by increasing air circulation and reducing the use of artificial lighting.
Lifestyle and Behavioral Adjustments
Making lifestyle and behavioral adjustments can also contribute to maintaining healthy indoor air quality. Avoiding smoking indoors, using natural cleaning products, and reducing the use of air fresheners and candles can all help reduce the amount of harmful chemicals in the air. Opening windows and doors to allow fresh air in can also help improve air circulation and reduce the buildup of pollutants.
By implementing these best practices, individuals can take steps to maintain healthy indoor air quality and promote a strong immune system.
Regulations and Standards for Indoor Air Quality
Governmental Guidelines
In order to ensure that indoor air quality is safe and healthy, many governments have established guidelines for acceptable levels of various pollutants. The United States Environmental Protection Agency (EPA) has set standards for pollutants such as carbon monoxide, nitrogen dioxide, and particulate matter. These standards are based on extensive research and are designed to protect public health.
Other countries have similar guidelines. For example, the European Union has established guidelines for pollutants such as benzene, formaldehyde, and ozone. These guidelines are designed to protect the health of EU citizens and are enforced by member states.
Industry Certifications and Ratings
In addition to governmental guidelines, there are also industry certifications and ratings that can help consumers choose products and services that promote healthy indoor air quality. For example, the Carpet and Rug Institute (CRI) has established a certification program for carpets and rugs that meet certain standards for low emissions of volatile organic compounds (VOCs).
The Leadership in Energy and Environmental Design (LEED) program, established by the United States Green Building Council, provides certification for buildings that meet certain environmental standards, including indoor air quality. The program has different levels of certification, with higher levels indicating greater environmental sustainability.
Overall, these regulations and certifications are important for ensuring that indoor air quality is healthy and safe for occupants. By following these guidelines and choosing certified products and services, consumers can promote better immune system health and overall well-being.
Frequently Asked Questions
What are the impacts of volatile organic compounds on immune system health?
Volatile organic compounds (VOCs) are common indoor air pollutants released by various household products and building materials. Exposure to VOCs can lead to respiratory irritation, headaches, and other health issues. Studies have also shown that long-term exposure to VOCs can weaken the immune system, making individuals more susceptible to infections and illnesses.
How do particulates in indoor environments influence respiratory immunity?
Particulate matter (PM) is a type of air pollutant that consists of small particles suspended in the air. Exposure to PM can lead to respiratory problems, including asthma and lung cancer. Particles can also enter the bloodstream and cause damage to the immune system. Individuals with weakened immune systems, such as the elderly and children, are particularly vulnerable to the effects of PM.
In what ways can exposure to sulfur dioxide indoors affect immune health?
Sulfur dioxide (SO2) is a common indoor air pollutant released by burning fossil fuels. Exposure to SO2 can cause respiratory irritation and aggravate existing respiratory conditions. Studies have also shown that long-term exposure to SO2 can weaken the immune system, making individuals more susceptible to infections and illnesses.
What is the relationship between nitrogen dioxide levels indoors and immune system function?
Nitrogen dioxide (NO2) is a type of air pollutant commonly found indoors, especially in homes with gas stoves. Exposure to NO2 can lead to respiratory problems, including asthma and bronchitis. Studies have also shown that exposure to NO2 can weaken the immune system, making individuals more susceptible to infections and illnesses.
How does the presence of ozone in indoor air impact the body’s immune response?
Ozone (O3) is a type of air pollutant that can be found indoors and outdoors. Exposure to high levels of ozone can cause respiratory irritation and aggravate existing respiratory conditions. Studies have also shown that exposure to ozone can weaken the immune system, making individuals more susceptible to infections and illnesses.
What are the health risks associated with poor indoor air quality in relation to autoimmune diseases?
Autoimmune diseases are conditions in which the immune system attacks healthy cells in the body. Poor indoor air quality can exacerbate autoimmune diseases by weakening the immune system and increasing inflammation in the body. Individuals with autoimmune diseases should take extra precautions to ensure good indoor air quality, such as using air purifiers and avoiding exposure to common indoor air pollutants.